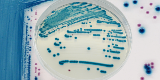

クロモアガーTM 酵素基質培地

CHROMagar™ 社は、2015 年に関東化学のグループ会社になりました。
1979年から始まった酵素基質培地のパイオニア!
1979年に Dr. A. Rambach は大腸菌検出用の培地を開発し、特許を取得しました。この技術は、臨床分野や食品分野の重要な病原菌検査用培地に応用され微生物検査に革命をもたらしました。
微生物の検出に関して、分子生物学的手法等を使用した新技術が使用されてきておりますが、酵素基質培地の使用頻度は着実に増加しています。
培地に応用される発色の技術とは?




培地に応用される発色の技術とは、微生物のコロニーに特徴的な色を付け、細菌の識別をより簡単にするために開発された技術です。Dr A.Rambachは微生物が持つ酵素の基質特異性と基質と色素から構成される無色の化合物(酵素基質)を利用することを考案しました。
目的とする微生物の持つ酵素が酵素基質を切断すると、遊離した色素が菌体内に沈殿します。その結果、形成されたコロニーは特徴的な色で呈色します。目的の微生物が特異的に持つ酵素をターゲットとすることで、集落の色調で他の微生物と区別することができます。また、集落の色調は可視光下、肉眼で観察が可能のため、従来の培地に比べ容易に目的の微生物を検出することができます。
クロモアガー™ 酵素基質培地のメリット
- 発色による鑑別により、客観性に優れます。
- 培地とコロニーのコントラストが良く判別が容易です。
- 反応が特異的です。
- 酵素による代謝反応は主に菌体内で生じるため、色素の拡散や近接するコロニーの影響がほとんどありません。
- 酵素基質を組み合わせることにより、一枚の培地で複数の微生物のスクリーニングが可能です。
微生物検査に関する
お問い合わせ
メールでのお問い合わせ
お電話でのお問い合わせ